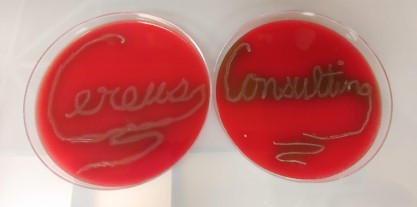
image of microscope and lab equipment

The clinical lab, especially microbiology, has been hit hard by events of the last few years. A rapidly evolving healthcare landscape has forced microbiology labs to shift priorities to meet changing needs and put prior plans on hold. In this new Covid19 world, visions of more efficient workflow, implementation of the newest technologies, and patient outcome improvement have been replaced by the reality of critical staffing shortages, tech burnout, and maximum effort to maintain the status quo.
We are ASCP certified, FL licensed microbiologists with extensive experience in the Micro lab including both management and working the bench within the past three years. We are in touch with the challenges faced by today's scarce resources in the Micro lab and can offer a hand so your staff can focus on patient care.
We have expertise with verifications of new tests, breakpoints, and instrumentation. We offer recommendations for improving workflow, consolidation of testing at one facility for multi-hospital systems, and inventory streamlining for cost savings. We can assist with procedures, specimen collection manuals, antibiograms and much more.
We can streamline your Microbiology operations to save time and money, increase efficiency and avoid tech burnout.
Don’t put off needed improvements due to an understaffed department. Let us talk to you today about our services.

Denise is an experienced Microbiologist turned infection preventionist who offers a unique perspective of lab operations as seen from the hospital operations side. Denise is licensed in the state of Florida as Clinical Lab Supervisor, ASCP and AMT certified in medical laboratory science, and board certified in infection control. Denise is one of the primary consultants of Cereus Microbiology Consulting, LLC.

